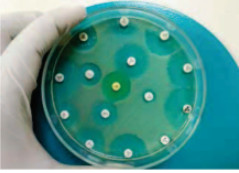

Lý thuyết Hóa học 10 bài 1 CTST
Chúng tôi xin giới thiệu bài Lý thuyết Hóa lớp 10 bài 1: Nhập môn Hóa học được VnDoc sưu tầm và tổng hợp các câu hỏi lí thuyết và trắc nghiệm có đáp án đi kèm nằm trong chương trình giảng dạy môn Hóa học lớp 10 sách CTST. Mời quý thầy cô cùng các bạn tham khảo tài liệu dưới đây.
Bài: Nhập môn Hóa học
A. Lý thuyết Hóa học 10 bài 1
1. Đối tượng nghiên cứu của Hóa học
* Nhận biết đối tượng nghiên cứu của hoá học
- Nghiên cứu thành phần
+ Đơn chất là những chất được tạo nên từ 1 nguyên tố hóa học. Đơn chất có thể chứa một hoặc nhiều nguyên tử của cùng một nguyên tố hóa học (Ví dụ: Lá nhôm, Bình khí nitrogen)
+ Hợp chất là những chất tạo nên từ 2 nguyên tố hóa học trở lên (Ví dụ: Cốc nước, Muối ăn)
- Nghiên cứu tính chất vật lý
+ Hiện tượng vật lí: là hiện tượng chỉ biến đổi về thể, trạng thái của chất, không có chất mới sinh ra.
- Nghiên cứu tính chất Hóa học
+ Hiện tượng hóa học: là hiện tượng biến đổi chất này thành chất mới.
→ Dấu hiệu chính để phân biệt hiện tượng vật lý và hiện tượng hóa học là có chất mới tạo thành.
Hoá học là ngành khoa học thuộc lĩnh vực khoa học tự nhiên, nghiên cứu về thành phần, cấu trúc, tính chất và sự biến đổi của chất cũng như ứng dụng của chúng.
* Củng cố: Khi đốt nến (được làm bằng paraffin), nến chảy ra ở dạng lỏng, thấm vào bấc, cháy trong không khí, sinh ra khí carbon dioxide và hơi nước. Cho biết giai đoạn nào diễn ra hiện tượng biến đổi vật lí, giai đoạn nào diễn ra hiện tượng vật lí, giai đoạn nào diễn ra hiện tượng biến đổi hóa học. Giải thích?
Hướng dẫn giải
- Nến chảy ra chuyển từ thể rắn sang thể lỏng → Sự chuyển thể, không có sự tạo thành chất mất
→ Biến đổi vật lí
- Nến cháy trong không khí, sinh ra chất mới là CO2 và H2O → Có sự tạo thành chất mới
→ Biến đổi hóa học
2. Vai trò của Hóa học trong đời sống và sản xuất
* Tìm hiểu vai trò của hoá học trong đời sống và sản xuất
Hoá học có ứng dụng trong các lĩnh vực như sau:
- Dùng làm nhiên, vật liệu
- Bón phân cho cây trồng
- Thuốc phòng, chữa bệnh cho người
- Chỉ khâu tự tiêu được dùng trong y khoa
- Mỹ phẩm
- Nghiên cứu trong phòng thí nghiệm...
⇒ Hoá học có vai trò quan trọng trong đời sống, sản xuất và nghiên cứu khoa học.
* Củng cố: Kể tên một vài ứng dụng khác của hóa học trong đời sống.
Hướng dẫn giải
- Một vài ứng dụng khác của hóa học trong đời sống là:
+ Lấy vân tay tội phạm
+ Dùng cồn để sát khuẩn vết thương
+ Sử dụng chất phù hợp để dập tắt đám cháy xăng, khí gas
+ Bảo quản thực phẩm
+ Để hoa quả nhanh chín
3. Phương pháp học tập Hóa học
* Trình bày phương pháp học tập hoá học
Để học tốt môn Hoá học, chúng ta cần có phương pháp học tập đúng đắn thông qua một số hoạt động được thực hiện trên lớp học, cũng như ở nhà.
Thông qua một số hình thức sau:
- Ôn tập và nghiên cứu bài học trước khi đến lớp
- Rèn luyện tư duy hoá học
- Ghi chép
- Luyện tập thường xuyên
- Thực hành thí nghiệm
- Sử dụng thẻ ghi nhớ
- Hoạt động tham quan, trải nghiệm
- Sử dụng sơ đồ tư duy
* Phương pháp học tập hoá học nhằm phát triển năng lực hóa học, bao gồm:
(1) Phương pháp tìm hiểu lí thuyết
(2) Phương pháp học tập thông qua thực hành thí nghiệm
(3) Phương pháp luyện tập, ôn tập
(4) Phương pháp học tập trải nghiệm.
* Củng cố: Dựa vào các tiêu chí khác nhau, em hãy lập sơ đồ để phân loại các chất sau: oxygen, ethnol, iron (III) oxide, acetic acid, sucrose
Hướng dẫn giải
- Trạng thái ở điều kiện thường
|
Thể rắn |
Thể lỏng |
Thể khí |
|
Iron (III) oxide Sucrose |
Ethanol Acetic acid |
Oxygen |
- Chất vô cơ – hữu cơ
|
Chất vô cơ |
Chất hữu cơ |
|
Oxygen Iron (III) aicd |
Ethanol Acetic acid Sucrose |
- Đơn chất – Hợp chất
|
Đơn chất |
Hợp chất |
|
Oxygen
|
Ethanol Acetic acid Sucrose Iron (III) aicd |
4. Phương pháp nghiên cứu Hóa học
* Tìm hiểu phương pháp nghiên cứu hoá học
- Khi nghiên cứu một vấn để hoá học, chúng ta cần có phương pháp nghiên cứu.
- Không có phương pháp nào là chung cho mọi nghiên cứu.
- Tuỳ vào mục đích và đối tượng nghiên cứu mà chúng ta lựa chọn phương pháp cho phù hợp.
a. Phương pháp nghiên cứu lí thuyết là sử dụng những định luật, nguyên lí, quy tắc, cơ chế, mô hình,... cũng như các kết quả nghiên cứu đã có để tiếp tục làm rõ những vấn đề của lí thuyết hoá học.
b. Phương pháp nghiên cứu thực nghiệm là nghiên cứu những vấn để dựa trên kết quả thí nghiệm, khảo sát, thu thập số liệu, phân tích, định lượng, ...
c. Phương pháp nghiên cứu ứng dụng nhằm mục đích giải quyết các vấn đề hoá học được ứng dụng trong các lĩnh vực khác nhau.
* Tìm hiểu các bước nghiên cứu hoá học
Ví dụ: Để nghiên cứu thành phần hoá học và bước đầu ứng dụng tinh dầu tràm trà (Melaleuca alternifolia) trong sản xuất nước súc miệng, các nhà nghiên cứu đã thực hiện theo các bước được mô tả trong Hình 1.6:

(1) Nghiên cấu thành phần hóa học và ứng dụng của tinh dầu tràm trà làm nước súc miệng qua các công trình khoa học trên các tạp chí đã được xuất bản.

(2) Đặt giả thuyết tình đấu tràm trà có khả năng kháng khuẩn

(3) Thí nghiệm chiết xuất tinh dầu bằng phương pháp chưng
(4) Khảo sát hoạt tính kháng khuẩn của sản phẩm cắt lôi cuốn hơi nước nước súc miệng từ tinh dầu tràm trà.
Hình 1.6. Các bước thực hiện trong đề tài nghiên cứu thành phần hoá học và bước đầu ứng dụng tinh dầu tràm trà trong sản xuất nước súc miệng
Như vậy:
- Phương pháp nghiên cứu hóa học bao gồm: nghiên cứu lí thuyết, nghiên cứu thực nghiệm và nghiên cứu ứng dụng.
- Phương pháp nghiên cứu hoá học thường bao gồm một số bước:
(1) Xác định vấn đề nghiên cứu
(2) Nêu giả thuyết khoa học
(3) Thực hiện nghiên cứu (lí thuyết, thực nghiệm, ứng dụng)
(4) Viết báo cáo: thảo luận kết quả và kết luận vấn đề.
* Củng cố: Hãy chỉ rõ các bước nghiên cứu trong Hình 1.6 tương ứng với những bước nào trong phương pháp nghiên cứu hóa học
Hướng dẫn giải
- Bước 1: Nghiên cứu thành phần hóa học và ứng dụng của tinh dầu tràm trà làm nước súc miệng qua các công trình khoa học trên các tạp chí đã được xuất bản
- Bước 2: Nêu giả thuyết: tinh dầu tràm trà có khả năng kháng khuẩn
- Bước 3: Thực hiện nghiên cứu: tiến hành thí nghiệm chiết xuất tinh dầu và khảo sát hoạt tính kháng khuẩn của sản phẩm
B. Bài tập minh họa
Bài 1: Hóa học nghiên cứu về những vấn đề gì? Hóa học có vai trò như thế nào trong đời sống và sản xuất?
Hướng dẫn giải
- Hóa học nghiên cứu về thành phần, cấu trúc, tính chất và sự biến đổi của chất cũng như ứng dụng của chúng.
- Vai trò của hóa học trong đời sống và sản xuất
+ Là nhiên liệu dùng cho động cơ đốt trong
+ Làm vật liệu xây dựng
+ Ngành y tế: thuốc phòng, chữa bệnh cho người, chỉ khâu tự tiêu dùng trong y khoa
+ Làm mĩ phẩm, phân bón cho cây trồng
+ Nghiên cứu trong phòng thí nghiệm
Bài 2: Nội dung nào dưới đây không phải là đối tượng nghiên cứu của hóa học?
A. Thành phần, cấu trúc của chất
B. Tính chất và sự biến đổi của chất
C. Ứng dụng của chất.
D. Sự lớn lên và sinh sản của tế bào
Hướng dẫn giải
Hóa học nghiên cứu về thành phần, cấu trúc, tính chất và sự biến đổi của chất cũng như ứng dụng của chúng
→ Hóa học không nghiên cứu về sự lớn lên và sinh sản của thế bào
Bài 3: Em hãy nêu một số phương pháp học tập môn Hóa học mà em cho là mang lại hiệu quả cao?
Hướng dẫn giải
Các phương pháp học tập:
+ Phương pháp tìm hiểu lí thuyết
+ Phương pháp học tập thông qua thực hành thí nghiệm
+ Phương pháp luyện tập, ôn tập
+ Phương pháp học tập, trải nghiệm
Bài 4: Từ sáng sớm thức dậy cho đến tối đi ngủ, em sử dụng rất nhiều chất trong việc sinh hoạt cá nhân, ăn uống, học tập,… Hãy liệt kê những chất đã sử dụng hằng ngày mà em biết. Nếu thiếu đi những chất ấy thì cuộc sống sẽ bất tiện như thế nào?
Hướng dẫn giải
- Oxygen: Giúp duy trì hô hấp, sự sống ở con người và động vật
- Nước: Nếu thiếu nước, con người sẽ mắc các bệnh về bài tiết, cây trở nên khô héo và chết
- Iodine: Thiếu iodine, con người sẽ bị bướu cổ
- Glucose: Thiếu glucose, con người sẽ bị mất năng lượng
- Calcium: Phát triển xương, giúp xương chắc khỏe
Bài 5: Mưa acid là một thuật ngữ chung chỉ sự tích lũy của các chất gây ô nhiễm, có khả năng chuyển hóa trong nước mưa tạo nên môi trường acid. Các chất gây ô nhiễm chủ yếu là khí SO2 và NOx thải ra từ các quá trình sản xuất trong đời sống, đặc biệt là quá trình đốt cháy than đá, dầu mỏ và các nhiên liệu tự nhiên khác. Hiện tượng này gây ảnh hưởng trực tiếp đến đời sống con người, động – thực vật và có thể làm thay đổi thành phần của nước các sông, hồ, giết chết các loài cá và những sinh vật khác, đồng thời hủy hoại các công trình kiến trúc. Theo em, việc nghiên cứu để tìm ra giải pháp nhằm giảm thiểu tác hại của mưa acid thuộc phương pháp nghiên cứu lí thuyết, thực nghiệm, hay ứng dụng
Hướng dẫn giải
Nghiên cứu để tìm ra giải pháp nhằm giảm thiểu tác hại của mưa acid thuộc phương pháp nghiên cứu ứng dụng, nhằm mục đích giải quyết các vấn đề mưa acid gây nên (ảnh hưởng xấu đến môi trường, con người...)
------------------------------
Như vậy, VnDoc.com đã gửi tới các bạn Lý thuyết Hóa học 10 bài 1: Nhập môn Hóa học CTST. Ngoài ra, các em học sinh có thể tham khảo môn Hóa 10 Cánh Diều, Lý 10 Cánh Diều và Toán 10 Chân trời sáng tạo tập 1, Sinh 10 Chân trời sáng tạo đầy đủ khác.